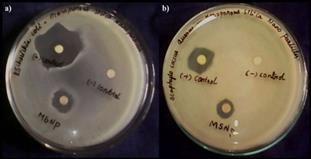
21
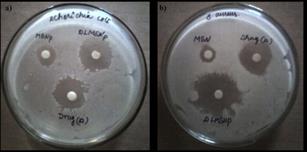
12
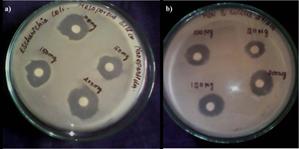
14
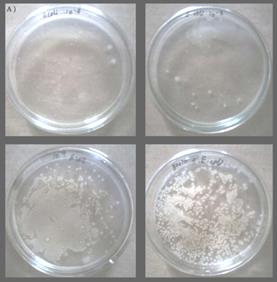
15

Int J Pharm Pharm Sci, Vol 8, Issue 5, 196-201 Original Article
SYNTHESIS OF MESOPOROUS SILICA NANOPARTICLES AND DRUG LOADING FOR GRAM POSITIVE AND GRAM-NEGATIVE BACTERIA
S. SHARMILADEVI1, A. SHANMUGA PRIYA2, M. V. SUJITHA3*
1,2,3PG and Research Department of Biotechnology and Bioinformatics, Holy Cross College, Bharathidasan University, Tiruchirappalli 620004, Tamil Nadu, India
Email: suji2014hcc@gmail.com
Received: 26 Mar 2015 Revised and Accepted: 30 Mar 2016
ABSTRACT
Objective: To synthesize mesoporous silica nanoparticles using the sol-gel method and to determine the antibacterial activity of mesoporous silica nanoparticles and tetracycline loaded mesoporous silica nanoparticles.
Methods: In the synthetic procedure, the surfactant Cetyl Trimethyl Ammonium Bromide (CTAB) is initially dissolved in basic aqueous solution, and the mixture is vigorously stirred. Tetra Ethyl Ortho Silicate (TEOS) is added, and the solution is kept stirring for 6 h. After the reaction is complete, the as-synthesized product is filtered and washed with deionized water. The antibacterial was tested using disc diffusion method and minimum bactericidal concentration (MBC).
Results: The synthesized mesoporous silica nanoparticles were characterized by using Scanning Electron Microscope (SEM) micrographs showed spherical particles with an average size of 350 nm. The powder X-Ray Diffraction (XRD) analysis of the material further confirmed the crystallinity of the mesopores as evidenced by the diffraction pattern of an intense peak at θ=24º. Fourier Transform Infra Red Spectroscopy (FTIR) indicated the involvement of carboxyl, amine and hydroxyl groups in the synthetic process. The result shows the inhibitory growth zone of 20 mm and 18 mm for tetracycline loaded mesoporous silica nanoparticles against Escherichia coli and Staphylococcus aureus respectively.
Conclusion: To summarize, it has been experimentally demonstrated that mesoporous silica nanoparticle and tetracycline loaded mesoporous silica nanoparticles show very good antimicrobial behavior against the gram-positive (Staphylococcus aureus) and gram negative (Escherichia coli) bacteria.
Keywords: Mesoporous silica nanoparticles, Sol-gel method, Drug loading, Antibacterial activity
© 2016 The Authors. Published by Innovare Academic Sciences Pvt Ltd. This is an open access article under the CC BY license (http://creativecommons.org/licenses/by/4.0/)
INTRODUCTION
Nanoparticles are being viewed as fundamental building blocks of nanotechnology. The most important and distinct property of nanoparticles is that they exhibit larger surface area to volume ratio. The most effective studied nanoparticles today are those made from noble metals, in particular, Ag, Pt, Au and Pd. In past decade, mesoporous silica materials have received growing attention due to their potential biomedical application [1]. Mesoporous silica is a form of silica, and it is used in recent development in nanotechnology [2]. Mesoporous silica nanoparticles have a unique properties, including high surface area, a tunable pore size and volume, stable mesoporous structure, well-defined surface properties and favorable biocompatibility [3]. The most common types of mesoporous silica materials, such as mobile composition of materials (MCM)-41/48, Santa Barbara amorphous silica (SBA)-15, Michigan State University silica (MSU)-n, Korean Institute of technology silica (KIT)-1 and folded sheet-derived mesoporous silica (FSM)-16 [4, 2]. The recently developed sol-gel technique for the synthesis of mesoporous silica nanoparticles has shown great promise to the biomedical application by offering new possibilities for embedding antibiotics within silica and for controlling their release from the host matrix into the surrounding medium. The composition of silica sol-gels that can be tuned and the fabrication method at low temperatures enable them to carry biologically active agents and to be useful as a drug delivery system [5] Their synthesis of mesoporous silica microsphere was based on the well-established stober reaction for the synthesis of monodisperse non-porous silica spheres. It has several fascinating properties such as large surface area, excellent mechanical and thermal stability, low hemolytic, low toxicity, high biocompatibility, high drug loading capacity, and highly permeable porous shell for easy loading and release of guest species. Design and synthesis of hollow micro-nanostructures have been intensively pursued in the past decade. As a special type of these materials, hollow mesoporous silica spheres (HMSS) have attracted increasing attention especially in drug delivery [6]. The structure of the composite nanoparticles acts as the drug loading core, the co-polymer-liposome serves as the gating shell [7]. That shell structure of mesoporous silica nanoparticles system has emerged as a promising drug system for cancer therapy [8]. The invention provides an antimicrobial delivery system that allows for delayed release of antibacterial agents from a single application of mesoporous silicate particle antibacterial delivery system include one or more amines group covalently bonded to the pores or the surface of the mesoporous silicate particles, wherein the amino acid influences the release rate of an antimicrobial agent [9]. The use of nanoparticles containing antibiotics has demonstrated numerous advantages. Nanoparticles are used in wide range of applications as an antibacterial agent in disinfecting devices, cosmetics, home appliances, electronics, catalysis, chemistry, energy, medicine and water treatment plants [19,21].
As the antibiotic is held into the nanoparticles, chemical composition and modifications on the nanoparticles surface enable to prolong, localize, target and have a protected drug interaction with the diseased tissue. In this way, higher antibiotic concentrations are attained in the targeted cells, managing to reduce the frequency of the dosages taken, reducing the drug side effects and fluctuation in circulating levels, thus improving the overall pharmacokinetics. Other benefits of this type of drug delivery systems applied to antibiotic therapy are the reduction of the antimicrobial resistance, the enhancement of the solubility of some antibiotics and the widener therapeutic index [10]. Recent advances in the field of nanotechnology have made it possible to detect microorganisms using nanoparticles functionalized with oligonucleotides complementary to the gene tags of microorganisms [20]. In the present investigation, we report the synthesis of mesoporous silica nanoparticles followed by its drug loading efficiency. Further is efficacy to inhibit gram-negative bacteria (Escherichia coli) and gram-positive (Staphylococcus aureus) were evaluated [11].
MATERIALS AND METHODS
Chemicals
Cetyl Trimethyl Ammonium Bromide and Tetra Ethyl Ortho Silicate was procured from Sigma Aldrich.
Synthesis of mesoporous silica nanoparticles
Mesoporous silica particles with organo-functionalized groups covalently bonded to the pores can be prepared by the procedure described below. N-Cetyl Trimethyl Ammonium Bromide (CTAB) 1 g was dissolved in 480 ml of deionized water. Sodium hydroxide (NaOH) 2 mol was added to CTAB solution, followed by adjusting the solution temperature to 80 °C. TEOS 5 ml was introduced dropwise to the surfactant solution. The mixture was allowed to stir for 6 h to give white precipitates (as synthesized thiol-Sphere). The solid product was filtered, washed with ethanol and deionized water and dried in air. To remove the surfactant template (CTAB), 1.5 g of as-synthesized thiol-Sphere was refluxed for 24 h in a solution of 9 ml of hydrochloric acid and washed with deionized water. The resulting surfactant-remove thiol mesoporous sillica material was placed under high vacuum to remove the remaining solvent in the mesopores.
Drug loadingmethod
Mesoporous silica nanoparticle (10 mg/ml) was dispersed into tetracycline aqueous solution (1 mg/ml). Tetracycline-loaded mesoporous silica nanoparticles were obtained by centrifugation; then the products were washed with deionized water twice to removed the tetracycline absorbed on the surface. The supernatant and the washing liquor were collected, and the residual tetracycline was evaluated by using the calibration curves of standard tetracycline solutions obtained by UV-Vis spectroscopy.
The drug loading efficiency was calculated from the following equation:
![]()
Scanning electron microscopy analysis
SEM was used to analyze the shape and size for the synthesized Mesoporous silica nanoparticle. The pellet was mixed properly and carefully placed on a glass coverslip followed by air-drying. The coverslip itself was used during scanning electron microscopy (SEM) analysis. The images of mesoporous silica nanoparticles were obtained in a scanning electron microscope (VGEA3 TESCAN).
X-ray diffraction (XRD) analysis
Synthesized mesoporous silica nanoparticles were subjected to XRD analysis. The XRD (REGAKU mini flex 600) studies were performed with, Cu Kα radiation (λ = 1.54 nm) in the 2θ range of 30–80 operate data voltage of 40 kV and a current of 30 mA.
Fourier transforms infrared spectroscopy (FTIR)
FTIR analysis of the mesoporous silica nanoparticles was carried out through the potassium bromide (KBr) pellet (FTIR grade) method in 1:100 ratio and spectrum was recorded using Jasco FT/IR-6300 Fourier transform infrared spectrometer equipped with JASCO IRT–7000 Infrared microscopes using transmittance mode operating at a resolution of 4 cm-1.
Antimicrobial activity studies
The disc diffusion method was used to screen the antibacterial activity of the synthesized mesoporous silica nanoparticles against gram-positive (Staphylococcus aureus) bacteria and gram negative (Escherichia coli) bacteria as test microorganisms. In vitro antibacterial activity was screened by using muller hinton agar (MHA) obtained from Himedia. The Muller hinton agar plates were prepared by pouring 15 ml of media into the sterile Petri dish plates. The plates were allowed to solidify for 5 min and 0.1% inoculum suspension was swabbed uniformly, and the inoculum was allowed to dry for 5 min. 50 µl concentration of test sample (mesoporous silica nanoparticles) was loaded on 0.5 cm sterile disc. The loaded disc was placed on the surface of the medium and the compound was allowed to diffuse for 5 min and the plates were kept for incubation at 37 °C for 24 h. At the end of incubation, inhibition zones formed around the disc were measured with a transparent ruler in millimeter.
MIC and MBC determination of tetracycline-loaded mesoporous silica nanoparticles
The minimum inhibitory concentration (MIC) was determined using micro broth dilution methods. The concentration of synthesized nanoparticles (1 to 5) dilution was prepared using tubes containing 750 µl of broth the tubes were inoculated with the suspension of standardized inocula were added and incubated at 37 °C for 24 h. minimum inhibitory concentrations were recorded as the lowest concentration of synthesized nanoparticles showing no visible growth in the broth. The minimum bactericidal concentration was determined by CFU method. From the corresponding MIC tubes (10-1, 10-2,10-3, 10-4, 10-5) take 0.5 ml of culture and gently speared on the muller hinton agar plates that plates incubated at 37 °C for overnight after the incubation colony forming units were counted, and the CFU/ml was calculated in all cases.
![]()
RESULTS AND DISCUSSION
Synthesis of mesoporous silica nanoparticles
Synthesis of mesoporous silica nanoparticles using sol-gel method was confirmed by the formation of white color precipitation after adding TEOS (Tetra Ethylene Ortho Silica) to CTAB solution while continuous stirring. The synthesis of MSNs is performed at a low surfactant concentration to make the assembly of the ordered mesophases strongly depends on upon the interaction between the cationic surfactant and the growing anionic oligomer orthosilicic acid, which in turn limits the assembly of mesophases to small sizes [12]. The first material reported by the mobile researchers (MCM-41) was micrometer-sized particles with spherically ordered mesopores [13].
Scanning electron microscopy analysis of mesoporous silica nanoparticles
A silica nanoparticle represents a new class of mesoporous silica nanomaterials with a hollow spherical and mesoporous structure. SEM image of mesoporous silica nanoparticles are shown in fig. 1. The mesoporous silica nanoparticles with a mean diameter of about 350 nm were synthesized using a Tetra Ethyl Ortho Silicate (TEOS) as the silica precursors and Cetyl Trimethyl Ammonium Bromide (CTAB) as the pore forming agent. When simply treated by Na2CO3 in the presence of CTAB in an appropriate concentration, as the solid Stober spheres were successfully converted into uniform hollow spheres [6, 14].

Fig. 1: SEM analysis of the synthesized mesoporous silica nanoparticles
The elemental analysis of the mesoporous silica nanoparticles was performed using the Energy Dispersive Spectrum on the SEM. Fig. 2 shows the EDS spectrum of the spherical nanoparticles prepared with CTAB as pore forming agent. The peaks around 0.5 kV and 1.9 kV are corresponding to the binding energies of O and Si, respectively. Silica has the weight percentage as 23.59 %. The rest of the lines of the EDS spectrum correspond to the other elements (Na, Br and Cl).

Fig. 2: EDS anylsis of synthesized mesoporous silica nanoparticles
X-ray diffraction (XRD) analysis of mesoporous silica nanopaticles
The X-ray diffraction pattern is used to determine the crystalline structure of the silica nanoparticles. Investigation of the XRD provides evidence of the presence of silica nanoparticles. The fig. 3 shows that the particles are crystalline in nature.

Fig. 3: Powder XRD–pattern of synthesized mesoporous silica nanoparticles
The intense peak at θ=24⁰ indicates the silica peak which represents the crystalline nature due to the smaller particle size effect and incomplete inner structure of the nanoparticles. XRD pattern observed for mesoporous silica nanoparticles a number of bragg’s reflections corresponding to the (111), (200), (220) sets of lattice planes are observed that may be indexed on the basic of fcc structure of mesoporous silica nanoparticles [8, 15].
Fourier transforms infrared spectroscopy (FTIR) analysis of mesoporous silica nanoparticles
The Fourier transform infrared (FTIR) spectra of synthesized mesoporous silica nanoparticles were recorded using a JASCO IR–7000 at room temperature using KBr pellets. Fig. 4 shows the FTIR spectra of,mesoporous silica nanoparticles, Tetracycline loaded mesoporous silica nanoparticles and Tetracycline. It can be seen that there is a very pronounced band appearing at 1066 cm-1, together with less pronounced bands at 795 cm-1 in the spectrum of MSN, corresponding to the vibration absorption of Si–O–Si groups. Tetracycline is confirmed by new bands at around 3376 cm-1, 3302 cm-1, 1457 cm-1, 1123 cm-1, 949 cm-1and 1356 cm-1a typical absorption peak of alcohols, phenols, amines, aromatic ring, carboxylic acids, esters, and alkanes respectively.
The Tetracycline loaded MSN spectrum is characterized by broadband around 3405 cm-1 corresponding to NH stretching vibration, two narrow bands at 2922 and 2852 cm-1 attributed to CH2 stretching vibrations, bands between 1750 and 1500 cm-1 corresponding to amide vibrations and a narrow peak at 1479 cm-1 indicating the presence of CO2-carboxylate groups.The peak intensity was high at 1636 cm-1 a typical absorption peak of NH bend (primary amines) and C–F vibration respectively.The presence of these broad peaks also confirms successful loading of drug into the nanoparticles.Where oxygen atom plays the role of a bridge between two silicon sites. Showing absorption bands at 1678 and 1627 cm-1 for the tetracycline have the aromatic ring [12, 16].
Study of antibacterial activity of mesoporous silica nanoparticles
Nanoparticles showed effective antibacterial activity both in gram negative and gram positive compared the Antibacterial activity of synthesized mesoporous silica nanoparticles against gram negative (Escherichia coli) and gram-positive (Staphylococcus aureus) bacteria reveals an antibacterial activity. The result indicated that, the mesoporous silica with the positive control (tetracycline) and negative control (DMSO). Form the result it was confirmed that, the effect of mesoporous silica nanoparticles is responsible for the effective antibacterial activity when compared with the positive control (tetracycline) and negative control (DMSO). The result shows (fig. 5) inhibition zone of mesoporous silica nanoparticles, positive control (Tetracycline) and no zone formation of negative control (DMSO) is presented.

Fig. 4(a): FTIR spectra of Mesoporous silica nanoparticles

Fig. 4(b): FTIR spectra of tetracycline

Fig. 4(c): FTIR spectra of tetracycline-loaded mesoporous silica nanoparticles
Fig. 5: Comparison between the positive control (Tetracycline), negative control (DMSO) and mesoporous silica nanopaticles against (a) Escherichia coli, (b) Staphylococcus aureus
The highest tetracycline loading efficiency (57 %) could be ascribed to the hollow cavity in the center of mesoporous silica nanoparticles. The invention provides an antimicrobial delivery system that allows for delayed release of antibacterial agents from a single application of mesoporous silicate particles antibacterial delivery system include one or more amines group covalently bonded to the pores or the surface of the mesoporous silicate particles, wherein the amino acid influences the release rate of an antimicrobial agent [8, 17]. Antibacterial activity of synthesized mesoporous silica nanoparticles against gram negative (Escherichia coli) and gram-positive (Staphylococcus aureus) bacteria reveals an antibacterial activity. The result indicated that tetracycline is loaded mesoporous silica nanoparticles showed effective antibacterial activity both in gram negative and gram positive compared with the drug (Tetracycline). From the result it was confirmed that the combined effect of mesoporous silica nanoparticles and tetracycline is responsible for the effective antibacterial activity when compared with the drug (Tetracycline) alone.
Fig. 6: Comparison between the mesoporous silica nanoparticles, drug (Tetracycline) and Tetracycline loaded mesoporous silica nanoparticles. (a) Escherichia coli, (b) Staphylococcus aureus
The result and images inhibition zone of mesoporous silica nanoparticles, tetracycline and tetracycline loaded mesoporous silica nanoparticles (fig. 6). The inhibition zone was found to be 10 mm for mesoporous silica nanoparticles, 15 mm for tetracycline and 20 mm for tetracycline mesoporous silica nanoparticles against Escherichia coli. The inhibition zone was found to be 5 mm for mesoporous silica nanoparticles, 10 mm for tetracycline and 18 mm for tetracycline mesoporous silica nanoparticles against Staphylococcus aureus.
Effect of concentration of tetracycline-loaded mesoporous silica nanoparticles on gram negative and gram positive bacteria
The result of the antibacterial activity of various concentrations of tetracycline-loaded mesoporous silica nanoparticles is shown in (table 1 and fig. 7). The most potent effect, related to tetracycline loaded mesoporous silica nanoparticles showed inhibition effect, against gram-negative bacteria (Escherichia coli) as well as gram positive bacteria (Staphylococcus aureus) in a similar degree of inhibition zone.
The inhibition zone was found to be 10, 12, 15 and 20 for 50, 100, 150, and 200 mg/ml concentration of mesoporous silica nanoparticles against gram-negative bacteria and the inhibition zone was found to be 8, 10, 13, and 15 mm for 50, 100, 150 and 200 mg/ml concentration against gram-positive bacteria. The result shows that the growth of the bacteria decreased with the increase in the concentration of tetracycline-loaded mesoporous silica nanoparticles.
Table 1: Antibacterial activity of tetracycline-loaded mesoporous silica nanoparticles
S. No. |
Test organisms |
Drug |
Drug (Tetracycline) loaded |
mesoporous |
silica |
nanoparticles |
50 mg/ml |
50 mg/ml |
100 mg/ml |
150 mg/ml |
200 mg/ml |
||
Zone of inhibition (mm) (mean±SD) |
||||||
1. |
Escherichia coli |
11.5±0.4 |
9.6±0.57 |
12.16±0.2 |
14.23±0.7 |
18.9±0.5 |
2. |
Staphylococcus aureus |
8.7±0.2 |
7.4±0.37 |
9.7±0.2 |
12.6±0.4 |
14.9±0.2 |
Each value represents the mean±SD of three replicates per treatment in three repeated experiments.
Fig. 7: Antibacterial activity of tetracycline-loaded mesoporous silica nanoparticles in different concentration. (a) Escherichia coli, (b) Staphylococcus aureus
Minimum bactericidal concentration (MBC) of tetracycline-loaded mesoporous silica nanoparticles
To determine the lowest concentration of tetracycline-loaded mesoporous silica nanoparticles that completely inhibit the visible growth of bacteria minimum bactericidal concentration was performed.
Fig. 8(a): MBC determination of tetracycline-loaded mesoporous silica nanoparticles against Escherichia coli
The MBC of tetracycline-loaded mesoporous silica nanoparticles against Escherichia coli and Staphylococcus aureus are shown in fig. 8. Minimum bactericidal concentration was measured by CFU/ml and the cell reduction was found to be 100%, 97 %, 90 %,72 % and 50 % for 10-1, 10-2, 10-3, 10-4and 10-5respectively for Escherichia coli and 100%,96%, 89%, 66%, 54% for 10-1, 10-2, 10-3, 10-4and 10-5respectively for Staphylococcus aureus.The result shows the antibacterial activity of tetracycline-loaded mesoporous silica nanoparticles against gram negative (Escherichia coli) was higher than compared to gram-positive (Staphylococcus aureus).

Fig. 8(b): MBC determination of tetracycline-loaded mesoporous silica nanoparticles against Staphylococcus aureus
The hollow mesoporous silica spheres have large surface area, high pore volume, and controllable structure parameters. The cationic surfactant plays critical roles in forming the hollow mesoporous structure. A formation mechanism involving the etching of solid SiO2 accelerated by cationic surfactant followed by the redeposition of dissolved silica species directed by cationic surfactant is proposed [6, 18]. A recent report has demonstrated the antibacterial activity of mesoporous silica nanoparticles on both Gram positive and Gram negative microbes. The mechanism of the antibacterial activity of mesoporous silica nanoparticles was attributed to the electrostatic interaction of phosphate groups on the microbial cell wall and the cationic head group of the mesoporous silica nanoparticles. Also, the organic tail region embeds itself in the lipid bilayer. This, in turn, leads to the free flow of electrolytes out of the microbe and causes the cell death. This is believed to be the mechanism of cell death [8, 19].
CONCLUSION
To summarize, in this study, we have successfully synthesized the mesoporous silica nanoparticles using the sol-gel method. The use of cationic surfactant, Cetyl Trimethyl Ammonium Bromide (CTAB) is critical to the formation of hollow mesoporous structure. Antibacterial activity of mesoporous silica nanoparticles and tetracycline loaded mesoporous silica nanoparticles was carried out using tetracycline as a positive control for gram-positive (Staphylococcus aureus) and gram negative (Escherichia coli) bacteria. The antibacterial studies suggest that the mesoporous silica nanoparticles can be used as potential drug candidature to treat various diseases.
ACKNOWLEDGEMENT
I would like to thank Mr. Dr. R. Karvembu, Professor, Department of Chemistry, National Institute of Technology, Tiruchirappalli, for providing FTIR spectroscopy facilities and National College, Tiruchirappalli, for providing facilities to use the SEM and EDS analysis.
CONFLICT OF INTERESTS
Declared none
REFERENCES
- Ghassan MS, Wasnaa HM, Thorria RM, Ahmed AA, abdul AHK, Abu BM. Green synthesis antibacterial and cytotoxic effects of silver nanoparticles using Eucalyptus chapmaiana leaves extract. Asian Pac J Trop Biomed 2013;1:58-3.
- Pakkath Abdul RS, Thiyagarajan D. Synthesis and characterization of silica nanocomposites for bone applications. Int Res J Pharm2012;5:173-7.
- Yunfeng J, Yangfei S, Baisong C, Daru L, Wuli Y. Redox and temperature controlled drug release from hollow mesoporous silica nanoparticles. Chem Eur J2013;19:15410-20.
- Supratim G, Brian GT, Victor SR. Mesoporous silica nanomaterial based biotechnological and biomedical delivery systems. Nanomedicine2007;2:99-1.
- Mohamed NS, Prabhakaean M, Ashish R, Hamzeh A. Silica-antibiotic hybrid nanoparticles for targeting intracellular pathogens. Antimicrob Agents Chemother2009;10:4270-4.
- Xiaoliang F, Cheng C, Zhaohui L, Pengxin L, Nanfeng Z. A cationic surfactant assisted selective etching strategy to hollow mesoporous silica spheres. Nanoscale 2010;3:1632-9.
- Xin W, Zhuyuan W, Dan Z, Shenfei Z, Lipihg Y. Ph and thermo dual stimuli responsive drug carrier based on mesoporous silica nanoparticles encapsulation in a copolymer lipid bilayer. Appl Mater Interfaces 2013;5:10895-3.
- Tian X, Michael K, Monty L, Huan M, Sanaz K, Saji G. Polyethyleneimine coating enhances the cellular uptake of mesoporous silica nanoparticles allowed safe delivery of siRNA and DNA constructs. Am Chem Soc 2009;10:3273-6.
- Camporotodi DE, Foglia ML, Alvarez GS, Mebert AM, Diaz LE, Coradin T, et al. Antimicrobial properties of silica modified nanoparticles. Sci Technol Edu2013;1:283-90.
- Salome E, Rainer PL, Murry JH, Martin JL, Markus S. Antimicrobial properties of a novel silver silica nanocomposite material. Appl Environ Microbiol2009;9:2973-6.
- Brian GT, Chad MW, Victor SY. Morphological control of room temperature ionic liquid templated mesoporous silica nanoparticles for controlled release of antibacterial agents. Am Chem Soc2004;11:2139-3.
- Brian GT, Igor IS, Supratim GC, Victor SY. Synthesis and functionalization of mesoporous silica nanoparticles based on the Sol gel process and applications in controlled release. Acc Chem Res2007;9:846-3.
- Asep BD, Soon-Gil K, Ferry I, Kikuo O. Synthesis of spherical mesoporous silica nanoparticles with nanometer-size controllable pores and outer diameters. Micropor Mesopor Mater 2009;120:447-3.
- Krzysztof C, Magdalena P, Agata M, Xuecheg C, Anna W, Jonna L. Mesoporous silica nanospheres functionalized by Tio2 as a photoactive antibacterial agent. J Nanomed Nanotechnol2013;6:1000182-8.
- Isabel IB, Maria VR, Natalia K, Osamu T, Artur S, Martin. Incorporation of antimicrobial compounds in mesoporous silica film monolith. Biomaterials2007;30:5719-6.
- Ismail AR, Vejayakumar P. Synthesis of silica nanoparticles by Sol gel size dependent properties surface modification and application in silica polymer nanocomposites. J Nanomaterials 2012;1-5. Doi.org/10.1155/2012/132424. [Article in Press]
- Pedro JR, Aitor U, Javier G, Carlos RZ, Francisco JA, Ignazcio RM. An antibacterial coating based on a polymer/Sol-gel hybrid matrix loaded with silver nanoparticles. Nanoscale Res Lett 2011;6:305-2.
- Yu-Chin L, Liang-Yi L, Ming-Yi G, Yi-Ping F. Mesoprous silica nanoparticles synthesized from liquid crystal display manufacturing extracts as a potential candidate for a drug delivery carrier: evaluation of their safety and biocompatibility. Int J Nanosci2013;8:3833-2.
- Vithiya K, Rajendran K, Shampa S. Bacillus sp. Mediated extracellular synthesis of silver nanoparticles. Int J Pharm Sci 2014;6:525-7.
- Kanthadeivi A, Sathish KA, Aarrthy M, Raghaventhra R, Subhshini K. One step green synthesis of phytochemicals mediated gold nanoparticles from Aegle marmales for the prevention of urinary catheter infection. Int J Pharm Sci 2014;6:700-6.
- Sundararajen B, Ranjitha BD. Biosynthasis of silver nanoparticless in Lagerstroemia speciosa(L.) pers and their antimicrobial activities. Int J Pharm Pharm Sci 2014;6:30-4.